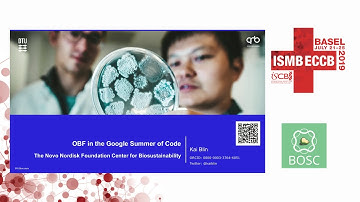
The OBF & OBF in the Google Summer of... - Heather Wiencko & Kai Blin - OBF: BOSC - ISMB/ECCB 2019

⬇ DOWNLOAD NOW
Jika muncul iklan pop-up, tutup lalu klik tombol kembali
Download lagu Open Bioinformatics Foundation Update - BOSC - ISMB 2024 secara gratis hanya untuk keperluan promosi. Dukung artis favorit kamu dengan membeli musik original di iTunes atau platform resmi lainnya.
 Open Bioinformatics Foundation update – BOSC – ISMB/ECCB 2023
Open Bioinformatics Foundation update – BOSC – ISMB/ECCB 2023 Opening Remarks - BOSC - ISMB 2024
Opening Remarks - BOSC - ISMB 2024 BOSC2024 S0b Heather Wiencko, Open Bioinformatics Foundation Update
BOSC2024 S0b Heather Wiencko, Open Bioinformatics Foundation Update BOSC2025 S0b Peter Cock, Open Bioinformatics Foundation update
BOSC2025 S0b Peter Cock, Open Bioinformatics Foundation update BOSC 2022 S0 Chris Fields Open Bioinformatics Foundation update
BOSC 2022 S0 Chris Fields Open Bioinformatics Foundation update The Open Bioinformatics Foundation - Hilmar Lapp - BOSC - ISMB/ECCB 2017
The Open Bioinformatics Foundation - Hilmar Lapp - BOSC - ISMB/ECCB 2017 BOSC2024 S3bc Avishai Weissberg, GenomeKit, a Python library for fast and easy access to genomic res
BOSC2024 S3bc Avishai Weissberg, GenomeKit, a Python library for fast and easy access to genomic res The OBF & OBF in the Google Summer of... - Heather Wiencko & Kai Blin - OBF: BOSC - ISMB/ECCB 2019
The OBF & OBF in the Google Summer of... - Heather Wiencko & Kai Blin - OBF: BOSC - ISMB/ECCB 2019